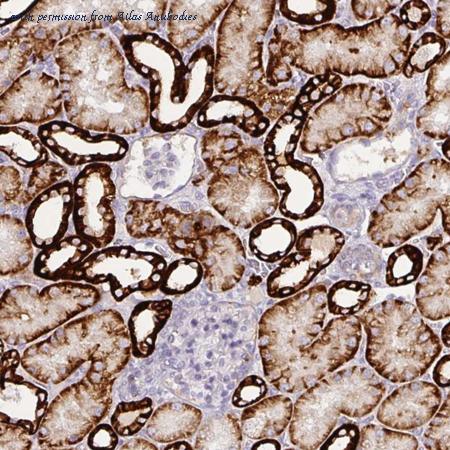
atlas antibodies hpa008773 图像 1

008773

中银景泰回报混合008773
图片尺寸540x340
中银景泰回报混合008773
图片尺寸540x340
中银景泰回报混合(008773) - 行情中心 - 搜狐基金
图片尺寸530x374
报名编号:008773
图片尺寸640x472
南阳日报多媒体数字报刊平台,南阳日报多媒体数字报刊
图片尺寸400x599
长丰首家网安警务室挂牌成立为网络安全护航
图片尺寸1000x666
dickies工装裤 多袋脚口罗纹收口休闲裤 工装裤男dk008773 卡其色 030
图片尺寸790x1209
dickies工装裤 多袋脚口罗纹收口休闲裤 工装裤男dk008773 青苔绿 030
图片尺寸790x843
dickies工装裤 多袋脚口罗纹收口休闲裤 工装裤男dk008773 卡其色 030
图片尺寸790x1247
dickies工装裤 多袋脚口罗纹收口休闲裤 工装裤男dk008773 青苔绿 030
图片尺寸790x989
atlas antibodies hpa008773 图像 1
图片尺寸450x450
dickies工装裤 多袋脚口罗纹收口休闲裤 工装裤男dk008773 青苔绿 030
图片尺寸790x838
dickies 多袋收口工装裤 dk008773
图片尺寸880x880
dickies工装裤 多袋脚口罗纹收口休闲裤 工装裤男dk008773 青苔绿 030
图片尺寸790x837
tag标签: 1 24 id编号:008773 尺寸:4320 x 7680
图片尺寸373x746
dickies工装裤 多袋脚口罗纹收口休闲裤 工装裤男dk008773 卡其色 030
图片尺寸790x1179
dickies工装裤 多袋脚口罗纹收口休闲裤 工装裤男dk008773 青苔绿 030
图片尺寸790x969
dickies工装裤 多袋脚口罗纹收口休闲裤 工装裤男dk008773 卡其色 036
图片尺寸800x800
公司货号:be008773 拉线赛车(2色) 价格: 会员才能查看
图片尺寸400x300
国内代购dickies迪凯斯春季男式束脚休闲长裤工装裤dk008773
图片尺寸300x300